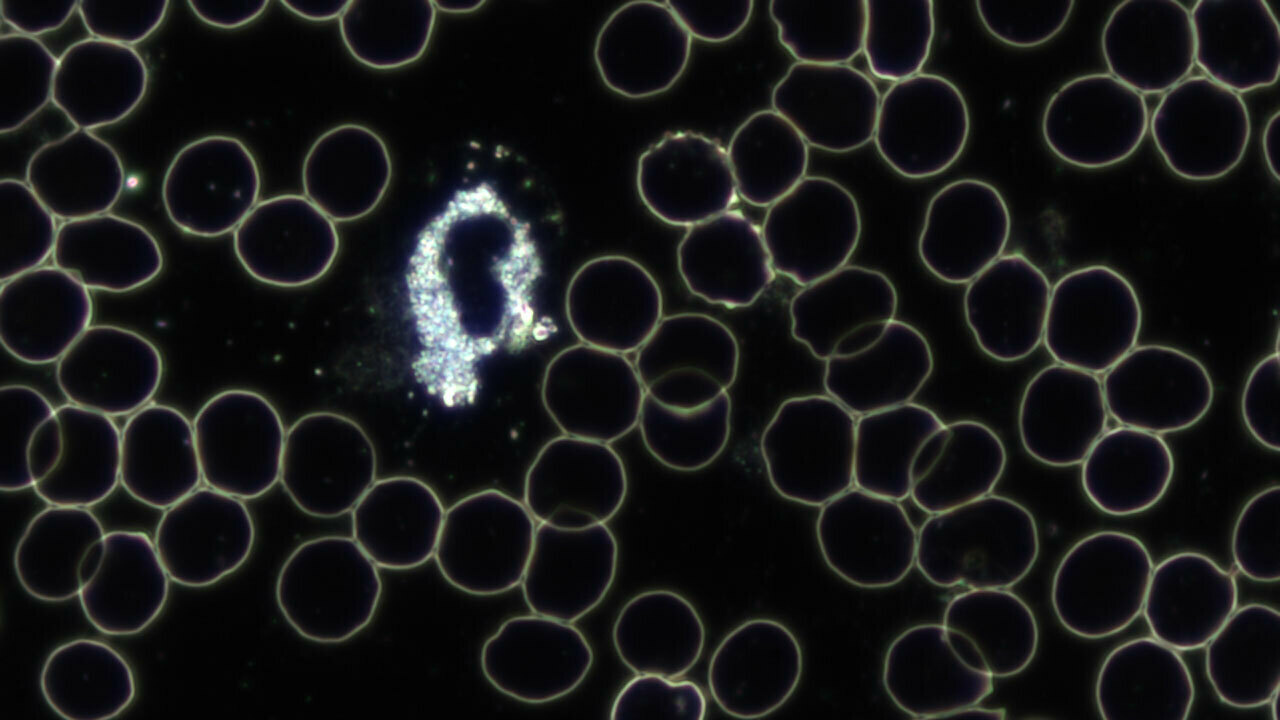
Imagem do serviço

Yapton Pharmacy, BN18 0EY, Arundel
Mostrar no mapa157 Aldershot Road, Church Crookham, GU52 8JS, Fleet
Mostrar no mapaMemorial Hall Sandy Ln, Church Crookham, Fleet , GU52 8LD
Mostrar no mapaBOTH Flu and Covid Vaccine (At the same appointment) Over 75, immunosuppressed or pregnant
Flu Vaccine Only (Over 65 years of age or with qualifying clinical conditions)
Covid Vaccine Only (over 75 or immunosuppressed)
Gesundheitsberatung nach H.v.B. (Erstberatung)
Gesundheitsberatung nach H.v.B. (Kontrolle)
Dunkelfeld-Analyse (Erstberatung)
Küchenplanung im Einrichtungshaus
Einrichtungsplanung im Einrichtungshaus
Büro & Objekteinrichtungen im Einrichtungshaus

Málaga, 26 Calle Salitre
Málaga, 26 Calle SalitreMálaga, 26 Calle Salitre
Mostrar no mapaC/ Salitre 26, local, 29002, Málaga
Mostrar no mapa1小時(遊戲時間50分鐘+10分鐘講解簽署)
30分鐘(遊戲時間25分鐘+10分鐘講解簽署)
1小時(遊戲時間50分鐘+10分鐘講解簽署)
Softball Hitting
Softball Fielding
Softball Pitching

Lagoa, Rua da Tecnologia K-Epsilon, 2, Rosário
Lagoa, Rua da Tecnologia K-Epsilon, 2, RosárioLagoa, Rua da Tecnologia K-Epsilon, 2, Rosário
Mostrar no mapaRua Deficientes das Forças Armadas, 2695-713, Loures
Mostrar no mapaPrison Escape
Catacomb Jones
Las Vegas Robbery
jewelrybydesigns
Custom Jewelry Consultation
Gold & Jewelry Buying

plantspiritmed
Willkommen bei Plantpiritmed, der Adresse für Beratung und energetische Dienstleistungen in Wien! Unser Unternehmen wurde gegründet, um Ihnen eine ganzheitliche Erfahrung für Körper, Geist und Seele zu bieten. Wir verstehen uns als Brücke zwischen de